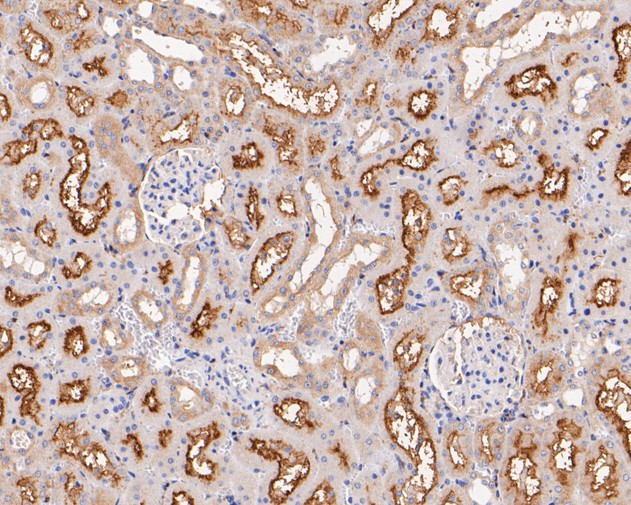
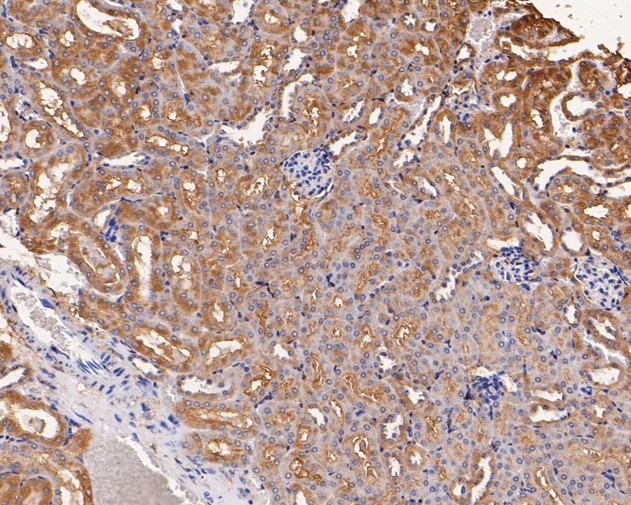

GABRB1 Rabbit Polyclonal Antibody

cat.: ER1901-66
| Product Type: | Rabbit polyclonal IgG, primary antibodies |
|---|---|
| Species reactivity: | Human, Mouse, Rat |
| Applications: | WB, IF-Cell, IHC-P, FC |
| Clonality: | Polyclonal |
| Form: | Liquid |
| Storage condition: | Shipped at 4℃. Store at +4℃ short term (1-2 weeks). It is recommended to aliquot into single-use upon delivery. Store at -20℃ long term. |
| Storage buffer: | 1*PBS (pH7.4), 0.2% BSA, 50% Glycerol. Preservative: 0.05% Sodium Azide. |
| Concentration: | 1ug/ul |
| Purification: | Immunogen affinity purified. |
| Molecular weight: | Predicted band size 54 kDa. |
| Isotype: | IgG |
| Immunogen: | Synthetic peptide within Human GABRB1 aa 327-376 / 474. |
| Positive control: | Rat brain tissue lysates, 293T, LOVO, rat kidney tissue, human skin tissue, human breast tissue, human breast carcinoma tissue, human kidney tissue, mouse kidney tissue, mouse heart tissue, SH-SY5Y. |
| Subcellular location: | Postsynaptic cell membrane, cell membrane. |
| Recommended Dilutions:
WB IF-Cell IHC-P FC |
1:500-1:2,000 1:50-1:200 1:50-1:200 1:50-1:100 |
| Uniprot #: | SwissProt: P18505 Human | P50571 Mouse | P15431 Rat |
| Alternative names: | AW061132 B230208N19Rik GABA(A) receptor beta 1 GABA(A) receptor subunit beta-1 GABA-A receptor, beta-1 polypeptide Gabrb-1 GABRB1 Gamma aminobutyric acid (GABA) A receptor beta 1 Gamma Aminobutyric Acid A Receptor Beta 1 Gamma Aminobutyric Acid Receptor , beta-1 Gamma-aminobutyric acid (GABA) A receptor, subunit beta 1 Gamma-aminobutyric acid receptor subunit beta-1 GARB1 GBRB1_HUMAN |
Images

|
Fig1: Western blot analysis of GABRB1 on rat brain tissue lysates. Proteins were transferred to a PVDF membrane and blocked with 5% BSA in PBS for 1 hour at room temperature. The primary antibody (ER1901-66, 1/500) was used in 5% BSA at room temperature for 2 hours. Goat Anti-Rabbit IgG - HRP Secondary Antibody (HA1001) at 1:5,000 dilution was used for 1 hour at room temperature. |

|
Fig2: ICC staining of GABRB1 in 293T cells (green). Formalin fixed cells were permeabilized with 0.1% Triton X-100 in TBS for 10 minutes at room temperature and blocked with 1% Blocker BSA for 15 minutes at room temperature. Cells were probed with the primary antibody (ER1901-66, 1/100) for 1 hour at room temperature, washed with PBS. Alexa Fluor®488 Goat anti-Rabbit IgG was used as the secondary antibody at 1/1,000 dilution. The nuclear counter stain is DAPI (blue). |

|
Fig3: ICC staining of GABRB1 in LOVO cells (green). Formalin fixed cells were permeabilized with 0.1% Triton X-100 in TBS for 10 minutes at room temperature and blocked with 1% Blocker BSA for 15 minutes at room temperature. Cells were probed with the primary antibody (ER1901-66, 1/100) for 1 hour at room temperature, washed with PBS. Alexa Fluor®488 Goat anti-Rabbit IgG was used as the secondary antibody at 1/1,000 dilution. The nuclear counter stain is DAPI (blue). |
|
Fig4: Immunohistochemical analysis of paraffin-embedded rat kidney tissue using anti-GABRB1 antibody. The section was pre-treated using heat mediated antigen retrieval with Tris-EDTA buffer (pH 8.0-8.4) for 20 minutes.The tissues were blocked in 5% BSA for 30 minutes at room temperature, washed with ddH2O and PBS, and then probed with the primary antibody (ER1901-66, 1/50) for 30 minutes at room temperature. The detection was performed using an HRP conjugated compact polymer system. DAB was used as the chromogen. Tissues were counterstained with hematoxylin and mounted with DPX. |

|
Fig5: Immunohistochemical analysis of paraffin-embedded human skin tissue using anti-GABRB1 antibody. The section was pre-treated using heat mediated antigen retrieval with Tris-EDTA buffer (pH 8.0-8.4) for 20 minutes.The tissues were blocked in 5% BSA for 30 minutes at room temperature, washed with ddH2O and PBS, and then probed with the primary antibody (ER1901-66, 1/50) for 30 minutes at room temperature. The detection was performed using an HRP conjugated compact polymer system. DAB was used as the chromogen. Tissues were counterstained with hematoxylin and mounted with DPX. |

|
Fig6: Immunohistochemical analysis of paraffin-embedded human breast tissue using anti-GABRB1 antibody. The section was pre-treated using heat mediated antigen retrieval with Tris-EDTA buffer (pH 8.0-8.4) for 20 minutes.The tissues were blocked in 5% BSA for 30 minutes at room temperature, washed with ddH2O and PBS, and then probed with the primary antibody (ER1901-66, 1/50) for 30 minutes at room temperature. The detection was performed using an HRP conjugated compact polymer system. DAB was used as the chromogen. Tissues were counterstained with hematoxylin and mounted with DPX. |

|
Fig7: Immunohistochemical analysis of paraffin-embedded human breast carcinoma tissue using anti-GABRB1 antibody. The section was pre-treated using heat mediated antigen retrieval with Tris-EDTA buffer (pH 8.0-8.4) for 20 minutes.The tissues were blocked in 5% BSA for 30 minutes at room temperature, washed with ddH2O and PBS, and then probed with the primary antibody (ER1901-66, 1/50) for 30 minutes at room temperature. The detection was performed using an HRP conjugated compact polymer system. DAB was used as the chromogen. Tissues were counterstained with hematoxylin and mounted with DPX. |

|
Fig8: Immunohistochemical analysis of paraffin-embedded human kidney tissue using anti-GABRB1 antibody. The section was pre-treated using heat mediated antigen retrieval with Tris-EDTA buffer (pH 8.0-8.4) for 20 minutes.The tissues were blocked in 5% BSA for 30 minutes at room temperature, washed with ddH2O and PBS, and then probed with the primary antibody (ER1901-66, 1/50) for 30 minutes at room temperature. The detection was performed using an HRP conjugated compact polymer system. DAB was used as the chromogen. Tissues were counterstained with hematoxylin and mounted with DPX. |
|
Fig9: Immunohistochemical analysis of paraffin-embedded mouse kidney tissue using anti-GABRB1 antibody. The section was pre-treated using heat mediated antigen retrieval with Tris-EDTA buffer (pH 8.0-8.4) for 20 minutes.The tissues were blocked in 5% BSA for 30 minutes at room temperature, washed with ddH2O and PBS, and then probed with the primary antibody (ER1901-66, 1/50) for 30 minutes at room temperature. The detection was performed using an HRP conjugated compact polymer system. DAB was used as the chromogen. Tissues were counterstained with hematoxylin and mounted with DPX. |

|
Fig10: Immunohistochemical analysis of paraffin-embedded mouse heart tissue using anti-GABRB1 antibody. The section was pre-treated using heat mediated antigen retrieval with Tris-EDTA buffer (pH 8.0-8.4) for 20 minutes.The tissues were blocked in 5% BSA for 30 minutes at room temperature, washed with ddH2O and PBS, and then probed with the primary antibody (ER1901-66, 1/50) for 30 minutes at room temperature. The detection was performed using an HRP conjugated compact polymer system. DAB was used as the chromogen. Tissues were counterstained with hematoxylin and mounted with DPX. |

|
Fig11: Flow cytometric analysis of GABRB1 was done on SH-SY5Y cells. The cells were fixed, permeabilized and stained with the primary antibody (ER1901-66, 1/50) (red). After incubation of the primary antibody at room temperature for an hour, the cells were stained with a Alexa Fluor 488-conjugated Goat anti-Rabbit IgG Secondary antibody at 1/1000 dilution for 30 minutes.Unlabelled sample was used as a control (cells without incubation with primary antibody; black). |
Note: All products are “FOR RESEARCH USE ONLY AND ARE NOT INTENDED FOR DIAGNOSTIC OR THERAPEUTIC USE”.